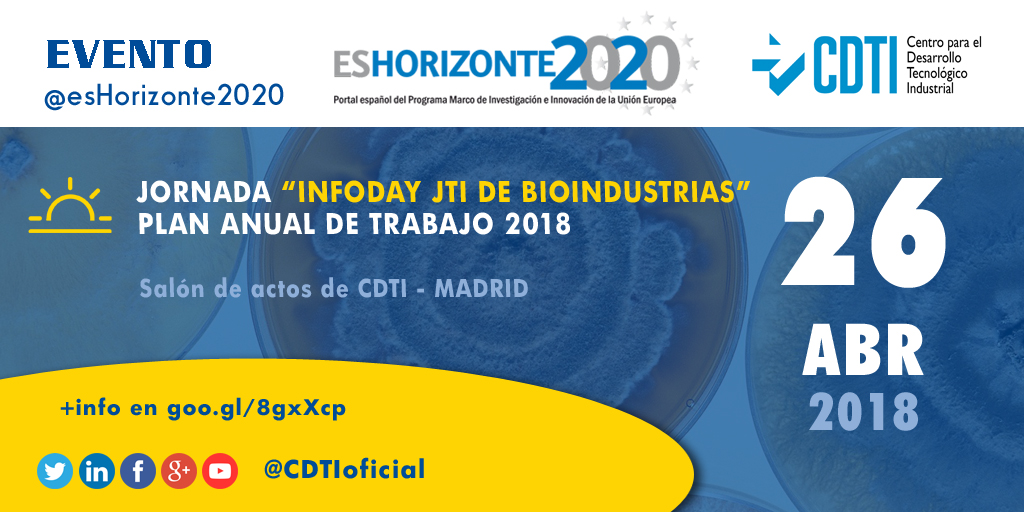
BIOINDUSTRIA | @CDTIoficial organiza un InfoDay de la JTI de @BBI2020 #bioeconomia

BIOINDUSTRIA | @CDTIoficial organiza un InfoDay de la JTI de @BBI2020 #bioeconomia
El próximo 26 de abril, @CDTIoficial organiza un InfoDay de la JTI BBI (Joint Technology Initiative on BioBased Industries). En esta jornada se repasará la Evolución de la JTI de BioIndustrias en España con sus logros y retos para el futuro. También se presentará el Plan de Trabajo de 2018, además de las características y novedades de la convocatoria, sus aspectos legales y financieros, casos de éxito y mucho más.
El evento tendrá lugar en el Salón de Actos del CDTI (C/ Cid, 4, 28001 Madrid).
La Iniciativa Tecnológica de BioIndustria (JTI-BBI) de H2020, es un PPP (Partenariado Público-Privado) entre la Comisión Europea y el Consorcio de BioIndustrias creado en 2014 para potenciar la Bioeconomía Europea.
El Centro para el Desarrollo Tecnológico Industrial (CDTI) es la Agencia Estatal de Innovación que asesora, financia e internacionaliza los proyectos empresariales de I+D e innovación de empresas y entidades españolas y gestiona la participación española en los organismos internacionales de I+D+I, como Horizonte2020 y Eureka, y en las industrias de la Ciencia y el Espacio.
+info en:
El evento tendrá lugar en el Salón de Actos del CDTI (C/ Cid, 4, 28001 Madrid).
La Iniciativa Tecnológica de BioIndustria (JTI-BBI) de H2020, es un PPP (Partenariado Público-Privado) entre la Comisión Europea y el Consorcio de BioIndustrias creado en 2014 para potenciar la Bioeconomía Europea.
El Centro para el Desarrollo Tecnológico Industrial (CDTI) es la Agencia Estatal de Innovación que asesora, financia e internacionaliza los proyectos empresariales de I+D e innovación de empresas y entidades españolas y gestiona la participación española en los organismos internacionales de I+D+I, como Horizonte2020 y Eureka, y en las industrias de la Ciencia y el Espacio.
+info en:
- @CDTIoficial Agencia Española de Innovación: sitio web– Twitter – Linkedin
- MINECO Ministerio de Economía, Industria y Competitividad: sitio web - Twitter
- H2020 en España: sitio web - Twitter - LinkedIn
- Consorcio de BioIndustria: sitio web - Twitter
- H2020: sitio web - Twitter
- Comisión Europea: sitio web - Twitter - LinkedIn
- Comisión Europea en España: sitio web - Twitter
- Marcadores: @CDTIoficial @_minecogob @EsHorizonte2020 @EU_H2020 @UEmadrid @EU_Commission @BBI2020 #bioeconomia
Este contenido es copyright © 2018 CDTI Centro para el Desarrollo Tecnológico Industrial, EPE. Está permitida la utilización y reproducción citando la fuente (CDTI) y la identidad digital de CDTI (@CDTIoficial).